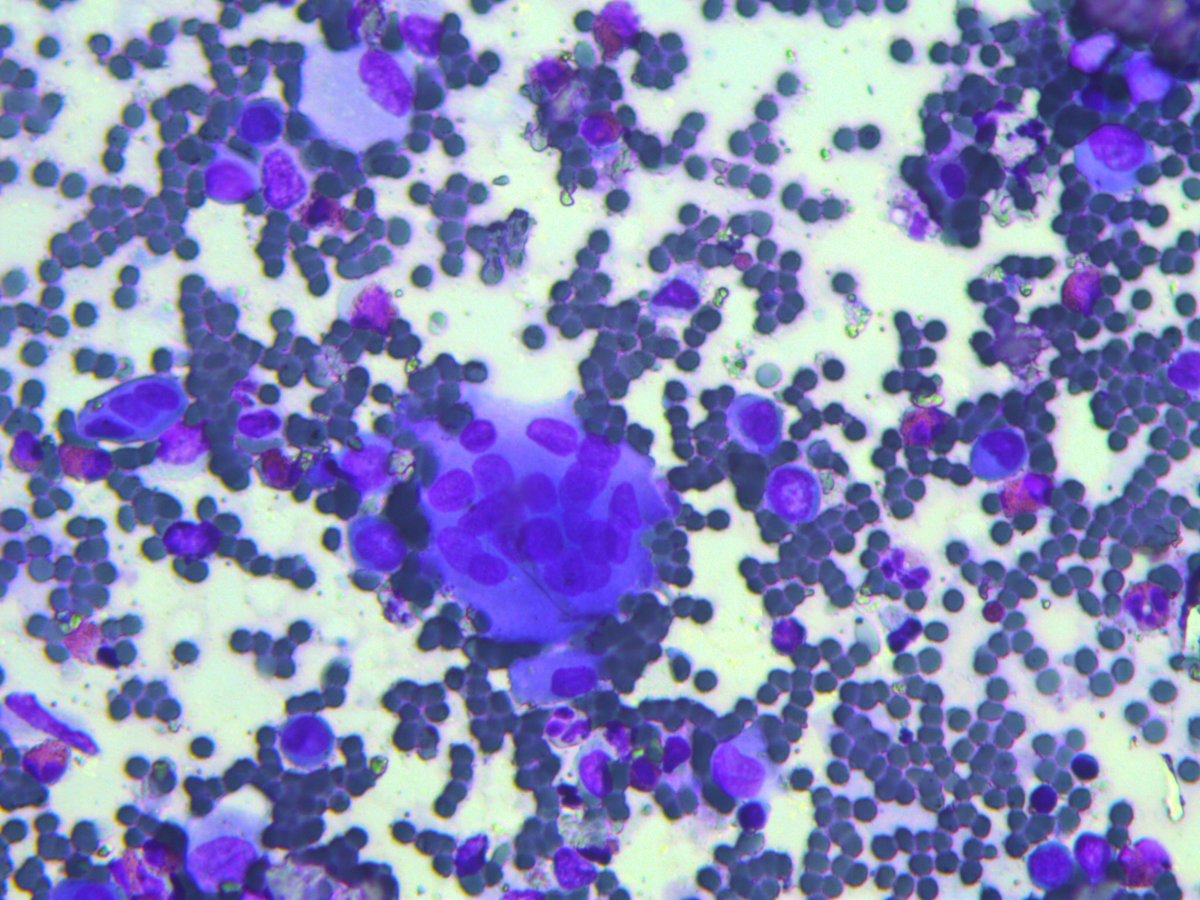
Rosliakova Elena tweet media

Rosliakova Elena
151 posts


Rosliakova Elena
@rep692
MD, PhD, Cytopathologist, FIAC, Tomsk Regional Oncology Center, Department of Pathology and Cytology
Tomsk Katılım Şubat 2016
179 Takip Edilen353 Takipçiler

CC281. The images correspond to 2 different patients, 2 different samples (upper vs lower images), and both are MEN. Love is in the air, so be careful when you breathe😷
What samples can they be? #cytopath
@kriyer68 @DrBMcGinn @goziemnweke @DrMarkOng @HENRYY_MD @GersonPaull_MD




English

@ksk_ny Good morning! Material at the parasitologist. I'll take a photo later
English

@rep692 Graceful sweeping curve of the microfilariae is suggestive of W.bancrofti. B.malayi is kinky with secondary curves.
Is there a higher magnification to confirm - this image appears to show something like the anterior and posterior V spot, but higher magnification can confirm this
English

#FNA of breast mass in a 30 year old woman. The pap stained slides are hypercellular with three dimensional cohesive clusters and large sheets of epithelial cells in a background of bipolar single cells demonstrating oval nuclei (myoepithelial cells) and some stromal fragments.



English